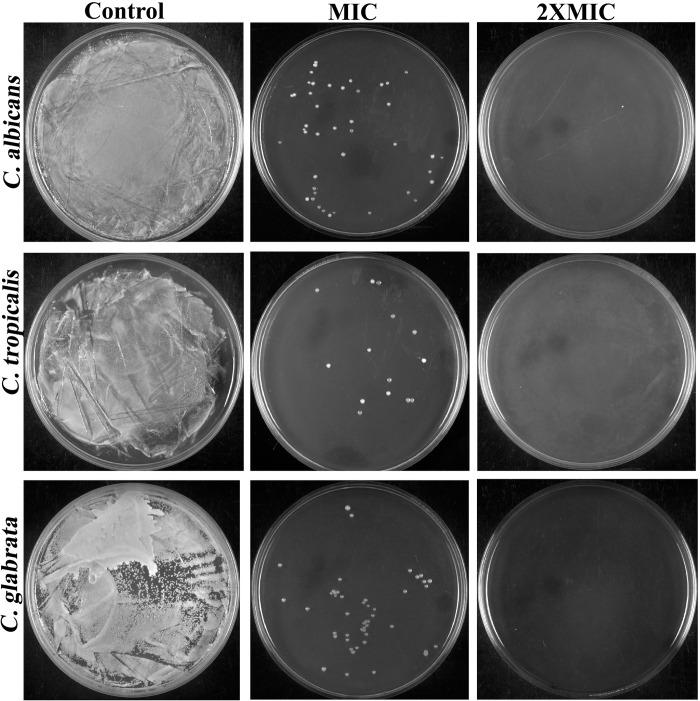
https://cdn.ncbi.nlm.nih.gov/pmc/blobs/aaca/10754460/2700e23f9090/pone.0295922.g002.jpg

3-溴丙酮酸通过活性氧介导抗真菌活性预防小鼠阴道念珠菌病。
ROS mediated anticandidal efficacy of 3-Bromopyruvate prevents vulvovaginal candidiasis in mice model.
机构信息
Department of Biotechnology, Science Campus, Alagappa University, Karaikudi, Tamil Nadu, India.
Department of Biomedical Sciences and Institute for Medical Science, Jeonbuk National University Medical School, Jeonju, South Korea.
出版信息
PLoS One. 2023 Dec 28;18(12):e0295922. doi: 10.1371/journal.pone.0295922. eCollection 2023.
Candidal infections, particularly vulvovaginal candidiasis (VVC), necessitate effective therapeutic interventions in clinical settings owing to their intricate clinical nature and elusive understanding of their etiological mechanisms. Given the challenges in developing effective antifungal therapies, the strategy of repurposing existing pharmaceuticals has emerged as a promising approach to combat drug-resistant fungi. In this regard, the current study investigates molecular insights on the anti-candidal efficacy of a well-proven anticancer small molecule -3-bromopyruvate (3BP) against three clinically significant VVC causing Candida species viz., C. albicans, C. tropicalis and C. glabrata. Furthermore, the study validates 3BP's therapeutic application by developing it as a vaginal cream for the treatment of VVC. 3BP exhibited phenomenal antifungal efficacy (killing >99%) with minimum inhibitory concentrations (MIC) and minimum fungicidal concentrations (MFC) of 256 μg/mL against all tested Candida spp. Time killing kinetics experiment revealed 20 min as the minimum time required for 3BP at 2XMIC to achieve complete-killing (99.9%) in all Candida strains. Moreover, the ergosterol or sorbitol experiment explicated that the antifungal activity of 3BP does not stem from targeting the cell wall or the membrane component ergosterol. Instead, 3BP was observed to instigate a sequence of pre-apoptotic cascade events, such as phosphatidylserine (PS) externalization, nuclear condensation and ROS accumulations, as evidenced by PI, DAPI and DCFH-DA staining methods. Furthermore, 3BP demonstrated a remarkable efficacy in eradicating mature biofilms of Candida spp., achieving a maximum eradication level of 90%. Toxicity/safety profiling in both in vitro erythrocyte lysis and in vivo Galleria mellonella survival assay authenticated the non-toxic nature of 3BP up to 512 μg/mL. Finally, a vaginal cream formulated with 3BP was found to be effective in VVC-induced female mice model, as it significantly decreasing fungal load and protecting vaginal mucosa. Concomitantly, the present study serves as a clear demonstration of antifungal mechanistic action of anticancer drug -3BP, against Candida species. This finding holds significant potential for mitigating candidal infections, particularly VVC, within healthcare environments.
白色念珠菌感染,特别是外阴阴道念珠菌病(VVC),由于其复杂的临床性质和对其病因机制的难以捉摸的理解,在临床环境中需要有效的治疗干预。鉴于开发有效抗真菌疗法的挑战,重新利用现有药物的策略已成为对抗耐药真菌的一种有前途的方法。在这方面,本研究调查了一种经过充分验证的抗癌小分子 3-溴丙酮酸(3BP)对三种临床上重要的 VVC 致病念珠菌物种(白色念珠菌、热带念珠菌和光滑念珠菌)的抗真菌功效的分子见解。此外,通过将 3BP 开发为治疗 VVC 的阴道乳膏,验证了其治疗应用的合理性。3BP 表现出惊人的抗真菌功效(杀菌率>99%),对所有测试的念珠菌属的最低抑菌浓度(MIC)和最低杀菌浓度(MFC)为 256 μg/mL。时间杀伤动力学实验表明,在 2XMIC 下,3BP 只需 20 分钟即可在所有念珠菌株中达到完全杀菌(99.9%)。此外,甾醇或山梨醇实验表明,3BP 的抗真菌活性并非源自细胞壁或膜成分麦角固醇。相反,观察到 3BP 引发了一系列凋亡前级联事件,如磷脂酰丝氨酸(PS)外化、核浓缩和 ROS 积累,这一点通过 PI、DAPI 和 DCFH-DA 染色方法得到了证明。此外,3BP 在外生成熟生物膜的清除方面表现出显著的功效,达到了 90%的最大清除水平。在体外红细胞裂解和体内金龟子幼虫存活试验中的毒性/安全性分析证明,3BP 在高达 512 μg/mL 的浓度下无毒性。最后,一种含有 3BP 的阴道乳膏在 VVC 诱导的雌性小鼠模型中被发现是有效的,因为它可以显著降低真菌负荷并保护阴道黏膜。同时,本研究清楚地展示了抗癌药物 3BP 对念珠菌属的抗真菌作用机制。这一发现为减轻医疗环境中的念珠菌感染,特别是 VVC,提供了重要的潜在应用。